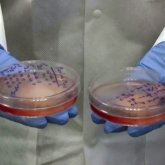
Жасанды еттен жасалған котлет мейрамхана қонақтарына ұсынылып жүр

Ресей ғалымдары
Тақырып бойынша жаңалықтар Ресей ғалымдары

Ухандық ғалымдар жарқанаттардың вирус тасымалдауы 2017 жылы басталғанын мойындады
18.01
Зерттеушілердің бірі оны жарқанат тістеген кезде, ол резеңке қолғапты «ине сияқты» тесіп жатқанын сезгенін айтады.